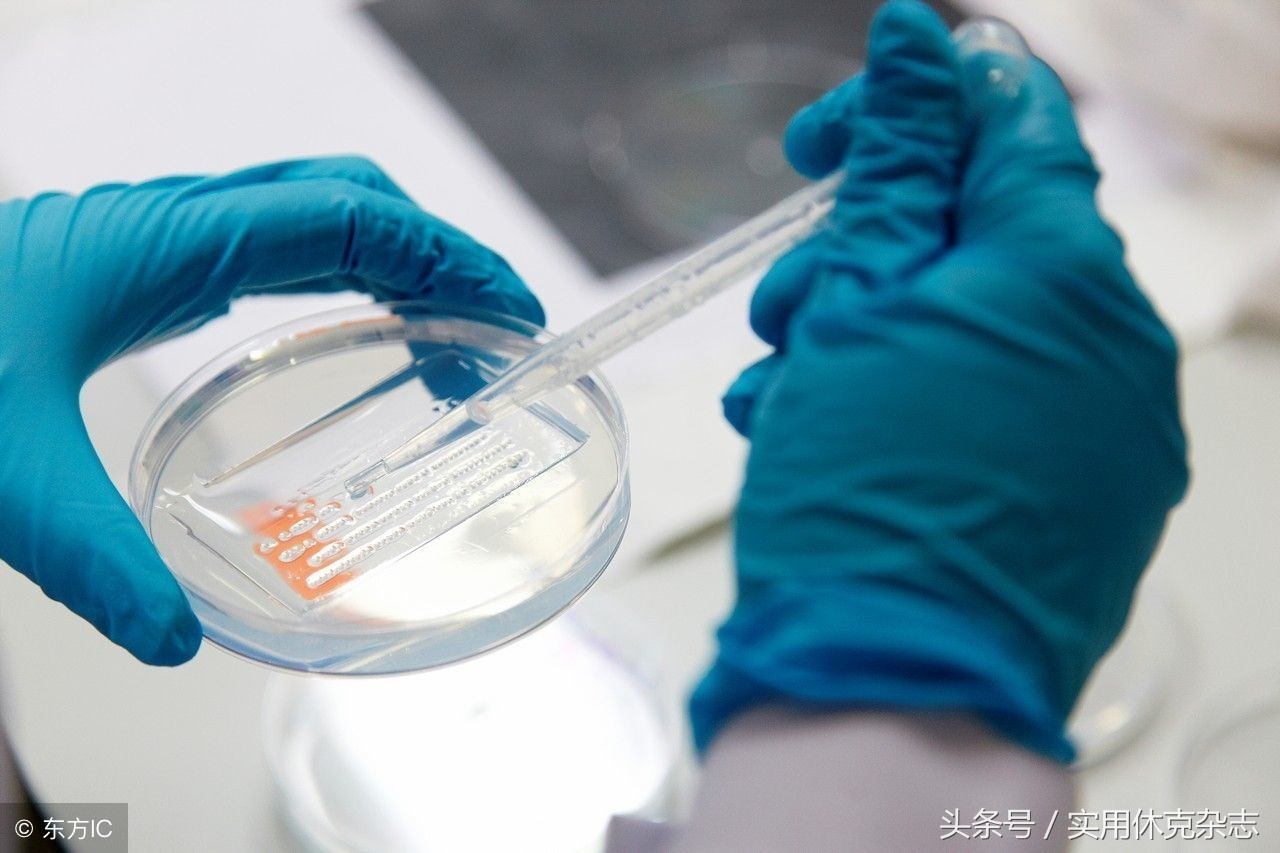
脓毒性休克与感染性休克的鉴别 (脓毒性休克要求多长时间纠正休克)

目前脓毒症(Sepsis)及脓毒性休克(Septic shock)依旧是临床亟需待以解决的重大问题,从1991年提出全身炎症反应综合征(systemic inflammatory response syndrome, SIRS)概念起,已走过近30年历程。
2004年,拯救脓毒症运动 (Surviving sepsis Campaign, SSC)发布了第一部指南,以后每隔4年更新一次,到2016年已至第4版。
最新指南依据更多、更大规模的临床试验,脓毒症定义表述为机体对感染反应失调所致危及生命的器官功能障碍[1],脓毒性休克为脓毒症的一个阶段,以循环、细胞、代谢功能障碍为突出表现,临床出现持续的低血压,尽管经过积极的容量复苏,但血乳酸的水平仍然超过2mmol/L,还需要应用血管活*药性**物以维持平均动脉压 (MAP)在65mmHg水平[2]。
虽然有关脓毒性休克的研究很多,但在病理生理、诊断、治疗等方面还存在着不确定因素,还有争议,还待完善。
本文仅就有关脓毒性休克近年来的中西医研究作一阐述。

(《实用休克杂志》2017年10月 第1卷 第1期 创刊号 专家论坛)
一、现代医学研究进展
(一)早期识别与液体管理
在脓毒性休克早期,越早发现休克及越快开始液体复苏,对预后有显著改善已是临床共识,但如何早期识别脓毒性休克是关键问题。微循环障碍是休克的特征之一,Ospina-Tascon等在一项研究中应用舌下视频显微镜早期发现微循环障碍,从而启动液体复苏治疗[3]。早期目标导向治疗(early goal-directed therapy, EGDT)下的液体复苏既往被认为是一项有效措施[4-5],并被写入指南。但2014年ProCESS、ProMIse、MARISE等多中心大样本随机对照研究中发现,EGDT与常规治疗相比60天死亡率与90天病死率无统计学差异,从而对EGDT方案的有效性提出质疑[6-8]。EGDT最早由Rivers等2001年在《新英格兰杂志》发表,该研究提出,对符合纳入标准的严重脓毒症或感染性休克患者进入急诊就诊后,要在最初的6小时内实现以下四个目标为靶向的治疗[9],即①中心静脉压(CVP)8~12mmHg;②平均动脉压(MAP)≥65mmHg;③尿量≥0.5mL/(kg·h);④中心静脉血氧饱和度(ScvO2)≥70%。但此研究是小样本量、单中心、单盲临床研究,同时在统计学过程中有选择性偏倚,且要在6小时内完成相应的有创操作,达到既定目标,在临床具体实施有困难。近年的一项EDGT-Meta[10]分析显示,这种治疗方式并不能明显改善预后。按照Rivers等设计,为了达到EDGT目标,在72小时内的累积液体量可能会达到34L晶体液。虽然理论上根据Frank-Starling曲线,通过增加血管容量,可以增加心输出量,并改善器官组织的灌注,但在脓毒性休克中,可能存在只有50%的患者对容量有反应性[11]。对大容量复苏没有反应性的患者来说,则可能会导致“盐水浸泡”,从而增加病死率[12]。虽然EDGT近年来的研究越来越展现出局限性,但事实上EDGT并非无效,也有Meta分析显示,EGDT能显著降低严重脓毒症和感染性休克患者的病死率。故有学者认为,即便在ProCESS和ARISE的研究中,其“常规治疗组”早期液体复苏量也至少达到了 30ml/kg,这两项研究与EGDT的治疗理念并不矛盾,研究中早期液体复苏策略也是积极的。虽然围绕EGDT的争论还在继续,但有一点可以肯定:脓毒性休克早期识别及尽快实施积极的液体复苏是有益的,这也是最新指南在治疗最初3小时,液体负荷容量为30ml/kg的推荐理由。
对复苏液体的选择,人工胶体已基本被排除[13]。晶体溶液由于其有效性和廉价、易得等优点,作为脓毒性休克患者液体复苏首选,但应用时也存在一定问题:如晶体溶液均由钠、氯离子等组成,大量应用可能引起高钠血症、高氯血症、酸中毒等不良反应,还对凝血功能、肾功能、胃肠功能和呼吸功能等都有影响。另由于相对分子质量小,晶体溶液能通过受损的毛细血管半透膜,导致血管内液体扩容后的长期可维持性降低[14]。而天然胶体如白蛋白的相对分子质量较大,能更有效保持血管内液体,扩容持续时间也久,与晶体溶液相比,白蛋白可以更好地增加胶体渗透压和中心静脉压,并降低心率。但有研究显示:对脓毒性休克的28天、90天死亡率,入住ICU时间,呼吸机使用时间,肾替代治疗发生率等方面,使用白蛋白较晶体液并无优势[15]。有研究表明白蛋白较生理盐水更易促进血流动力学稳定,对脓毒症亚组分析时亦发现白蛋白更易维持脓毒症患者循环稳定[16]。考虑到费用及血制品可能带来的不良反应,白蛋白还不是首选复苏液。

(配图,仅供参考)
(二)血流动力学监测
脓毒性休克患者早期容量复苏后,还需持续监测血流动力学,且脓毒症患者可能会合并有ARDS及心肌损伤,要保证合适的容量状态,指导正确合理选择血管活*药性**物、正性肌力药物等,就必须要有准确的血流动力学监测手段的介入。目前认为,既往EGDT中所提出的CVP、SVO2 及MAP目标,有很大的局限性,因此,早期治疗3小时后,对血流动力学评估指标是广泛的、不具体的,且未设定具体目标[2]。虽然如此,应用血流动力学的监测手段来指导液体复苏,还是有非常重要的意义。早在50多年以前,肺动脉漂浮导管 (pulmonary artery catheters, PAC)已经在临床广泛应用,但该项监测技术对于改善患者的最终临床结局并不理想。脉搏指示的连续心排出量监测(pulse indicator continuous cardiac output, PiCCO)技术,整合跨肺动脉的热稀释技术 (transpulmonary thermodilution technique, TPTD)和持续的进行脉搏波形的分析技术,并能动态的监测心排出量、前后负荷、心脏功能等综合指标,全面反映血流动力学和心脏舒缩功能的变化,从而能够准确的帮助临床医生评估患者的容量状态,指导脓毒性休克患者的液体复苏治疗。

(配图,仅供参考)
(三)心肌细胞损伤及治疗
虽然脓毒性休克早期表现为高心排量 (CO)、低血管张力、低血容量,以容量分布性休克为特征,但如果早期休克未能及时纠正,很快会出现低心排量、高血管张力的外周低灌注状态,到这个阶段休克更是难以纠正。导致这种情况的主要原因之一是心脏受抑,研究显示,脓毒性休克患者存在心肌酶的异常升高,与多种因素相关:①脓毒症炎症因子瀑布样释放直接损害心肌细胞;②应用血管活*药性**物增加组织氧耗,从而加重心肌细胞缺氧和损伤;③大量、快速的液体复苏治疗,虽然可以使心室充盈压力及心肌张力迅速升高,但也可导致心肌细胞受损;④休克时肾素血管紧张素的过度激活加重心肌负担。脓毒性休克患者的心肌受抑甚至可能出现在既往无心脏疾病的患者。对这类患者,决定预后重要因素之一是CO,正性肌力药物多巴酚丁胺,对改善心肌收缩力有显著帮助,但也可引起心肌氧耗增加、各类心律失常等副作用。新型钙增敏剂左西孟坦,在增加CO同时,对心肌氧耗需求的增加不高,还具有抗炎、抗氧化、抗细胞凋亡作用,对肝肾等脏器也有保护作用[17]。一项RCT的Meta分析也显示了左西孟坦能提高严重脓毒症/脓毒性休克患者的生存率[18]。但一项多中心、大型、随机RCTLeoPARDS显示:与对照组相比,左西孟坦并不能改善严重脓毒症/脓毒性休克患者脏器功能,28天病死率也无差异。同时左西孟坦显著延长呼吸机使用时间,并有更多的室上性心率失常[19]。因此,目前正性肌力药物还是选用多巴酚丁胺[2],对左西孟坦等新型药物的疗效还需要进一步临床研究。
(四)糖皮质激素的使用
脓毒性休克可能有50%的患者存在有肾上腺功能不全,采用ACTH刺激试验可以对肾上腺皮质功能进行评估。但有研究显示类固醇应用和ACTH试验之间的相互作用无明显统计学意义[20],而采用随机皮质醇水平检测对绝对肾上腺皮质功能不全患者是有效的,但对于相对肾上腺皮质功能不全的脓毒性休克患者尚未证实有指导意义[21]。既往研究显示生理剂量的糖皮质激素可以改善脓毒性休克患者的血流动力学参数和生存率[22],荟萃研究分析,低剂量糖皮质激素并不能降低病死率[23] 。虽然对预后无明显改善,但有研究显示,糖皮质激素对血管升压药不敏感的脓毒性休克有一定治疗效果[24]。因此,只要在对液体复苏和血管活*药性**物反应差的情况下,脓毒性休克患者早期还是可以加用小剂量的糖皮质激素[25]。由于小剂量糖皮质激素应用于脓毒性休克染、电解质代谢紊乱和消化道出血等风险,当停用血管升压药时,应尽早逐渐减量的停用糖皮质激素。

(配图,仅供参考)
(五)基因组学研究
脓毒症及脓毒性休克是一类异质性疾病,其本质原因是基因的多态性。基因的多态性决定机体对应激打击的易感性、耐受性、临床表型及治疗反应的差异,目前的研究热点集中在编码肿瘤坏死因子(tumor necrosis factors, TNF)、移动抑制因子(migration inhibition factor)、血浆I型纤溶酶原激活物抑制因子-1(plasminogen activator inhibitor-1, PAI-1)和toll样受体(toll-like receptor, TLRs[26-27])。基因多态性最常见的是单核苷酸多态性 (single nucleotide polymorphism, SNP),TNF的SNP研究中常见的多态性位点有-308、-376和-238。一项纳入1057例白人血统危重病患者的研究发现,TNF位于-308的AA纯合子较其他基因型存在更高的病死率[28]。在机械通气患者中对以上3个位点检测发现,携带至少其中的一个等位基因与更早发生呼吸机相关性肺炎 (ventilator associated pneumonia, VAP)和脓毒症相关[29]。MIF具有拮抗糖皮质激素的作用,目前研究发现,-173位点CC基因型与脓毒症患者预后显著相关,GG基因型患者在非肺部和腹部来源的感染中死亡风险增加。另一项研究也证实,GG基因型会导致预后不良。血浆中高浓度的与脓毒症患者的不良预后相关,在PAI-1基因启动子区域4G/5G或4G/4G等位基因型与血浆中 PAI-1含量相关。有研究显示,4G/4G基因型患者血浆PAI-1的浓度以及脓毒症的病死率明显高于4G/5G或5G/5G基因型,同时4G/4G基因型与较高的血浆IL-1、TNF-α、PAI-1浓度相关[30]。TLR是一类超家族,主要识别革兰氏阳性球菌,研究最多的基因位点是-7202腺嘌呤与鸟嘌呤转换,+742的腺嘌呤与鸟嘌呤转换,以及+1804的鸟嘌呤与胸腺嘧啶位置的颠倒。有队列研究显示[31],-7202的G等位基因和+1804的T等位基因频率较小的纯合子患者死于革兰阳性球菌引起的脓毒症风险更大。另一项研究表明,-7202GG和+742GG基因型携带者发生感染性休克的风险更大,其临床表现是血液中C反应蛋白水平更高,白细胞介素-10水平较低。
(配图,仅供参考)
二、祖国医学研究进展
(一)病因与机制
传统医学无 “脓毒性休克”病名,但根据临床表现,可归为 “厥证”、 “喘脱”等范畴,王今达等将脓毒症中医病因病机概括为邪毒入侵,导致正邪交争、正气耗伤、邪毒阻滞、正虚邪实[32]。如热毒炽盛,为毒热证;如出现败血阻滞,为瘀血证;如出现脏腑虚损、阴阳逆乱,即为急性虚证。赵淳指出,脓毒症 “病机多为素体正气亏虚,脏腑功能失调,阴阳气血失衡,复外感邪毒、创伤、大手术等使热、毒、瘀、湿等内犯机体,正虚邪实,正不胜邪,气机逆乱而发病,严重者脏器受损,甚者阴阳离决[33]。”方邦江从传统中医学亢害承制理论分析:严重脓毒症早期出现的应激反应和炎症反应可视为机体的一种保护机制,但反应过度而失控,出现太过或矫枉过正则造成急性阴阳失衡,亢而为害,继而机体为了不使炎症反应过于激烈会诱发抗炎机制进行承制[34]。然而严重脓毒症诱发的免疫麻痹则反映的是正气无力抗邪的急性虚证状态,病机特点为本虚标实,表现为 “邪毒炽盛,正气已虚”。
(二)辨证分型
王金达根据发病机制,分为三个证型:瘀血证、毒热证和急性虚证。陈雪认为脓毒症主要辨证分型为脾胃气虚证、热毒内蕴证、腑实热证、血脉瘀阻证。郭琪钰等从观察脓毒症胃肠功能障碍入手,认为腑气不通、瘀血阻滞是导致严重脓毒症的关键因素。并将证型进一步细分为肠热腑实证、痰湿蕴脾证、胃热气滞、瘀滞胃肠证,虚证中脾胃气虚证。张俭等认为脓毒症以实证和虚实夹杂证多见,虚实夹杂证中邪实方面以痰、热、瘀、湿为主,正虚方面以气虚和气阴两虚为主。何煜舟则根据温病学说理论,脓毒性休克相当于外感热病的极盛期和后期,病机特点是温热、火毒炽盛,认为邪毒由气传营入血,内攻脏腑,热与血结,瘀热酿毒,伤阴损阳,正不胜邪,而致邪毒内闭,阳气外脱。因此中医诊型分为气营两燔证、毒瘀营血证、热损气阴证、正虚毒陷证。陈媛等则将三焦辨证应用于脓毒症。综上所述,邪毒证、血瘀证、火热证、虚证、腑实证是脓毒症最常见的证型。而不同证型临床死亡率也不尽相同,研究显示,当出现合并证如腑实证或在疾病后期出现有虚实夹杂或虚证时,病情更危重,死亡率更高。

(配图,仅供参考)
(三)中药单体治疗
根据脓毒性休克的病因病机,中药单体研究主要集中在清热解毒、活血益气类药物范围内。研究发现,川芎嗪可减轻脓毒性休克心肌细胞的炎症反应,改善脓毒症所致急性肺损伤、降低血浆MDA含量,提高SOD活性。丹参多酚酸盐能增加脓毒症模型大鼠内皮细胞NO释放,抑制内皮素的合成、释放,抑制凝血因子释放,阻断脓毒性休克中的两大病理环节:炎症因子的瀑布样释放和凝血功能紊乱。姜黄素可抑制脓毒症模型大鼠NF-kB活化,从而减轻后续的炎症反应。穿心莲内酯通过调控NF-kB通道,减少NO、IL6、TNFα等促炎因子的产生,从而抑制并减轻脓毒症炎症反应。苦参素降低脓毒症大鼠肺组织匀浆中脂质过氧化反应程度,使氧自由基产生减少,减轻肺损伤,减少脓毒性休克合并急性呼吸窘迫综合征 (ARDS)发生。黄芪多糖抑制TNFα诱导的ICMA-1、VCAM-1和NF-kB的表达,减轻血清中炎性因子水平,其机制可能与抑制TLR4/NF-kB信号转导通路的激活有关。人参皂苷Rg5抑制脓毒症模型大鼠NF-kB活性,下调炎性介质,减少脓毒症ARDS时的肺水肿,减轻肺损伤程度。
(四)中药复方治疗
根据辨证分型,复方研究集中于以活血化瘀、清热解毒、通腑泄下、益气扶阳等*法大**为指导的方药。方邦江等采用脓毒方,组方为大黄、丹皮、赤芍、红藤、金银花、人参等药味,治拟清热解毒、活血祛瘀、益气扶正,对脓毒性休克的炎症控制和减轻内毒素对脏器的损伤有疗效[35]。周健淞等应用清热解毒、活血化瘀之清瘟败毒饮,联合高容量血液滤过,对严重脓毒症/脓毒性休克患者炎症介质的清除和T淋巴细胞免疫功能的改善有显著疗效。李兰等采用以清热解毒、通腑泻下为主的自拟的通腑理肺汤 (由连翘、杏仁、黄芩、大黄、芒硝、厚朴等、三七等组成),联合纤维支气管镜肺泡灌洗,对因肺炎引起的脓毒症患者有效。王评等根据温阳益气、活血化瘀、通腑泄下法则,以温脾汤加味,对严重脓毒症/脓毒性休克患者后期免疫麻痹有效。陈银结等以大黄、肉桂、附子、生姜组方以寒温并用,泄下解毒,对重度脓毒症/脓毒性休克患者降低血C反应蛋白(CRP)、血浆降钙素原(PCT)有效,对脓毒性休克并发严重的胃肠功能紊乱也有显著作用。刘秋江等以通腑泄下的大承气汤加减治疗脓毒性休克患者,对患者APACHE2评分的改善及炎症因子的减轻有明显疗效。王东强等研究发现,有通腑泄热、清气凉营作用的凉膈散对脓毒症大鼠凝血机制、炎症因子均有作用。朱培庭等采用锦红片治疗腹腔来源的脓毒症感染,发现其有抗炎、增强免疫、降低渗出等多方面作用[36]。

(配图,仅供参考)
(五)中药注射剂治疗
目前对中药注射剂的研究多集中在血必净注射液、醒脑静注射液、参芪扶正注射液、参附注射液等数个中成药注射剂。血必净注射液是在名方血府逐瘀汤的基础上进一步研究的静脉制剂,由红花、赤芍、当归、川芎、丹参等成分组成,具有活血化瘀、疏通经络的作用。对脓毒性休克的患者,血必净已具有抗炎症因子过度释放、改善血管内皮功能、改善免疫功能、改善微循环、增加乳酸清除率和改善脓毒症患者预后的作用。醒脑静注射液来源于安宫牛黄丸,具有清热解毒功效、活血化瘀之效。研究发现醒脑静注射液通过抑制TNFα及NF-kB的转导,从而明显降低血清中炎症因子的血清含量;同时还具有抗凝、增强组织细胞耐缺氧能力。参芪扶正注射液主要组分为*党**参、黄芪,具有共奏益气温阳之效,研究证实参芪扶正注射液有调控血压、增强心肌收缩力、稳定循环的作用,可以显著减少脓毒性休克患者在液体复苏过程中晶体液和升压药用量,避免血管内液外渗。参附注射液来源于参附汤,为红参、黑附片提取物制剂,其有效成分为人参总皂甙和乌头类生物碱,参附注射液对脓毒性休克微循环紊乱有显著改善作用,从而改善各类组织氧代谢,减轻因脓毒症并发的心肌损伤、增强心肌收缩力,减轻动物模型的炎症反应。

(配图,仅供参考)
(六)外治法
针灸治疗是传统中医的一项独有的、具有简便廉效的外治法,研究已发现,通过针刺或电针刺激足三里、关元、天枢等穴位,对脓毒性休克患者有广泛的抗炎、调节免疫、保护重要脏器等作用。也有研究发现,中药吴茱萸外敷可抑制严重脓毒症的炎症水平,降低MODS发生率和病死率。
脓毒性休克时病死率较高,涉及炎症反应、免疫功能紊乱、凝血功能障碍的复杂病理过程。很多既往显示有效的现代医学治疗经临床进一步研究纷纷被否认。中医药治疗具有多靶点的优势,无论是复方、中成药或中药注射剂经过研究显示具有抗炎、改善微循环、增强心肌收缩力、免疫调节等多方面作用。但围绕中医药的临床研究大多为小样本及单中心的研究,因其方法学、统计学局限使结果准确性大打折扣,证据力度不强。中药组分,配伍方式、副作用等问题也待深入研究。脓毒性休克是危重病学研究热点及重点,相信未来会有更大的突破!(收稿日期:2017-08-27)
作者:方邦江 卜建宏
作者单位:方邦江 上海中医药大学附属龙华医院急诊科;卜建宏 上海中医药大学附属中医医院急诊科
通讯作者: 方邦江,fangbji@163.com
参考文献
|
[1] |
Singer M,Deutschman CS,Seymour CW,et al.The third international consensus definitions for sepsis and septic shock (Sepsis-3) [J]. JAMA,2016, 315(8): 801-810. |
|
[2] |
Rhodes A,Evans LE,Alhazzani W,et al.Surviving Sepsis Campaign:International guidelines for management of sepsis and septic shock:2016 [J]. Crit Care Med,2017 Mar;45(3):486-552. |
|
[3] |
Ospina-Tascon G,Neves A P,Occhipinti G,et al.Effects of fluids on microvascular perfusion in patients with severe sepsis[J].Intensive care Med,2010,36:949-955. |
|
[4] |
Dellinger R P,Levy M M,Carlet J M,et al.Surviving sepsis Campaing:international guidelines for management of severe sepsis and septic shock:2008[J].crit Care Med,2008,36(1):296-327. |
|
[5] |
Dellinger RP,LEVY M M,Rhodes A,et al.Surviving Sepsis Campaign:International Guidelines for Management of Severe Sepsis and septic shock[J].Crit care Med,2013,41:580-637. |
|
[6] |
ProCESS Investigatom,Yealy DM,Kellum JA,et al.A randomized trial of protocol-based care for early septic shock[J].N Eng J Med,2014,(18):1683-1693. |
|
[7] |
Mouncey PR,Obsborn TM,Power GS,et al.Trial of Early,goal-directed resuscitation for septic shock[J].N Engl Med,2015,372(14):1301-1311. |
|
[8] |
Peake SL,Delaney A,Bailey M,et al.Goal-directed resuscitation for patients with early septic shock[J].N Engl J Med,2014,371(16):1496-1506. |
|
[9] |
Rivers E,Nguyen B,Havstad S,et aI.Early goal-directed therapy in the treatment of severe sepsis and septic shock[J].N Engl J Med,2001,345(19):1368-1377. |
|
[10] |
Angus DC,Barnato AE,Bell D,et al.A systematic review and meta-ARISE,ProCESS and ProMISe investigators[J]. Intensive Care Med,2015, 41(9):1549-1560. |
|
[11] |
Marik PE,Cavallazzi R,Vasu T,et al.Dynamic changes in arterial waveform derived variables and fluid responsiveness in mechanically ventilated patients: a systematic review of the literature[J]. Crit Care Med,2009,37(9):2642-2647. |
|
[12] |
Marik PE.Iatrogenic salt water drowning and the hazards of a high central venous pressure[J].Ann Intensive Care,2014,4:21-29. |
|
[13] |
Myburgh J A,Finfer S,Bellomo R,et al.CHEST Investigators:Australian and New Zealand IntensIve Care Society Clinical Trials Group:Hydroxyethyl starch or saline for fluid resuscitation in intensive care[J].N Engl J Med,2012,367(20):1901-1911. |
|
[14] |
Zampiei FG,Park M,Azevedo LC.Colloids in sepsis: evenly distributed molecules surrounded by uneven questions[J].Shock, 2013, 39(Suppl 1):42-49. |
|
[15] |
Caironi P,Tognoni G,Masson S,et al.Albumin replacement in patients with severe sepsis or septic shock[J].N Engl J Med,2014, 370(15):1412-1421. |
|
[16] |
Finfer S,Mcevoy S,Bellom R,et al.Impact of albumin compared to saline on organ function and mortality of patients with severe sepsis[J].Intesive Care Med,2011,37(1):86-96. |
|
[17] |
Nieminen MS, Fruhwald S, Heunks LM, et al. Levosimendan: current data, clinical use and future development [J]. Heart Lung Vessel 2013;5:227-245. |
|
[18] |
Zangrillo A, Putzu A, Monaco F, et al. Levosimendan reduces mortality in patients with severe sepsis and septic shock: A meta-analysis of randomized trials. J Crit Care 2015;30:908-913. |
|
[19] |
Gordon AC, Perkins GD, Singer M, et al. Levosimendan for the Prevention of Acute Organ Dysfunction in Sepsis[J]. N Engl J Med 2016,375(17):1638-1648. |
|
[20] |
Chebbo A, Tan S, Kassis C, et al. Maternal Sepsis and Septic Shock[J]. Crit Care Clin, 2016, 32(1):119-135. |
|
[21] |
Sweeney DA, Natanson C, Banks SM,et al. Defining normal adrenal function testing in the intensive care unit setting: a canine study [J].Crit Care Med, 2010, 38(2):553-561. |
|
[22] |
Bollaert PE,Charpentier C,Levy B,et al.Reversal of late septic shock with supraphysiologic doses of hydrocortisone [J]. Crit Care Med,1998, 26(4):645-650. |
|
[23] |
Sligl WI,Milner DA Jr,Sundar S,et al.Safety and efficacy of corticosteroids for the treatment of septic shock:A systematic review and meta-analysis [J]. Clin Infect Dis, 2009,49(1):93-101. |
|
[24] |
Festti J,Grion CM,Festti L,et al.Adrenocorticotropic hormone but not high-density lipoprotein cholesterol or salivary cortisol was a predictor of adrenal insufficiency in patients with septic shock [J].Shock,2014,42(1):16-21. |
|
[25] |
Cabrera JL, Pinsky MR. Management of septic shock: a protocol-less approach [J]. Crit Care, 2015, 19:260-268. |
|
[26] |
Sutherland AM,Walley KR.Bench-to-bedside review:Association of genetic variation with sepsis[J].Crit Care,2009,13(2):210-219. |
|
[27] |
Carvalho JK,Moore DB,Luz RA,et al.Prediction of sepsis-related outcomes in neonates through systematic genotyping of polymorphisms in genes for innate immunity and inflammation:Anarrative review and critical perspective[J].Sao Panlo Med J,2013,131(5):338-350. |
|
[28] |
Watanabe E,Zehnbauer BA,Oda S,et al.Tumor necrosis factor-308 polymorphism(rsl800629)is associated with mortality and ventilator duration in 1057 caucasian patients[J].Cytokine,2012,60(1):249-256. |
|
[29] |
Kotsaki A,Raftogiannis M,Routsi C,et al.Genetic polymorphisms within tumor necrosis factor gene promoter region:A role for susceptibility to ventilator-associated pneumonia[J].Cytokine,2012,59(2):358-363. |
|
[30] |
Wingeyer SP,de Larranaga G,Cunto E,et al.Role of 4g/5g promoter polymorphism of plasminogen activator inhibitor-1(pai-1)gene in outcome of sepsis[J].Thromb Res,2010,125 (4):367-369. |
|
[31] |
Thompson CM,Holden TD,Rona G,et al.Toll-like receptor 1 polymorphisms and associated outcomes in sepsis after traumatic injury:A candidate genc association study[J].Ann Surg,2014,259(1):179-185. |
|
[32] |
.王今达,李志军,李银平. 从“三证三法”辨证论治脓毒症[J]. 中国危重病急救医学,200618(学,2006,18(11):643-644 |
|
[33] |
唐彬,李云华,彭映辉. 赵淳教授中西医结合救治脓毒症学术经验[J]. 中国中医急症,2010,19(6):984-985. |
|
[34] |
田雨,朱玲,陈浩,等.脓毒方治疗重症脓毒症30例临床研究.黑龙江医药,2011,24(2):278-280. |
|
[35] |
朱玲、田雨、陈浩,等.脓毒方治疗重症脓毒症的临床研究[J].中国实验方剂学杂志,2010,16(9):207-208. |
|
[36] |
方邦江.沪上名医朱培庭治疗危急疑难病经验.第1版.中国中医药出版.2015.11. |
投稿方式及地址
来稿请寄:杂志编辑部(邮政编码100034),本刊接受电子稿件网上投稿,电子信箱:syxkzz@126.com,网址:http://www.syxkzz.net,联系电话:0731-83929129/83929298。
投稿后应同时从邮局邮寄纸稿、单位介绍信及审稿费,并可从网上查询稿件状态,本刊收到稿件后将通过网络发送回执,邮寄地址:湖南省长沙市芙蓉区解放西路61号,邮编:410005。
(湖南医聊运维)